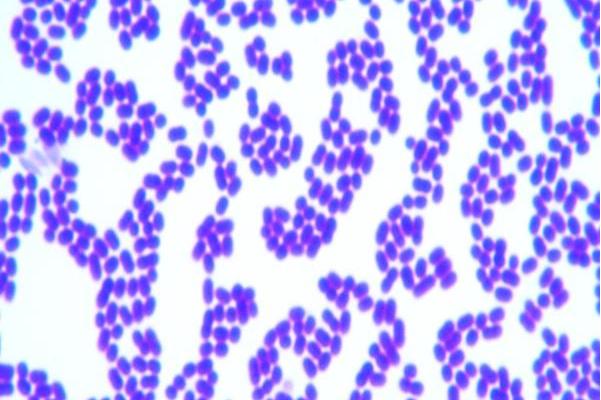
黄色金黄杆菌
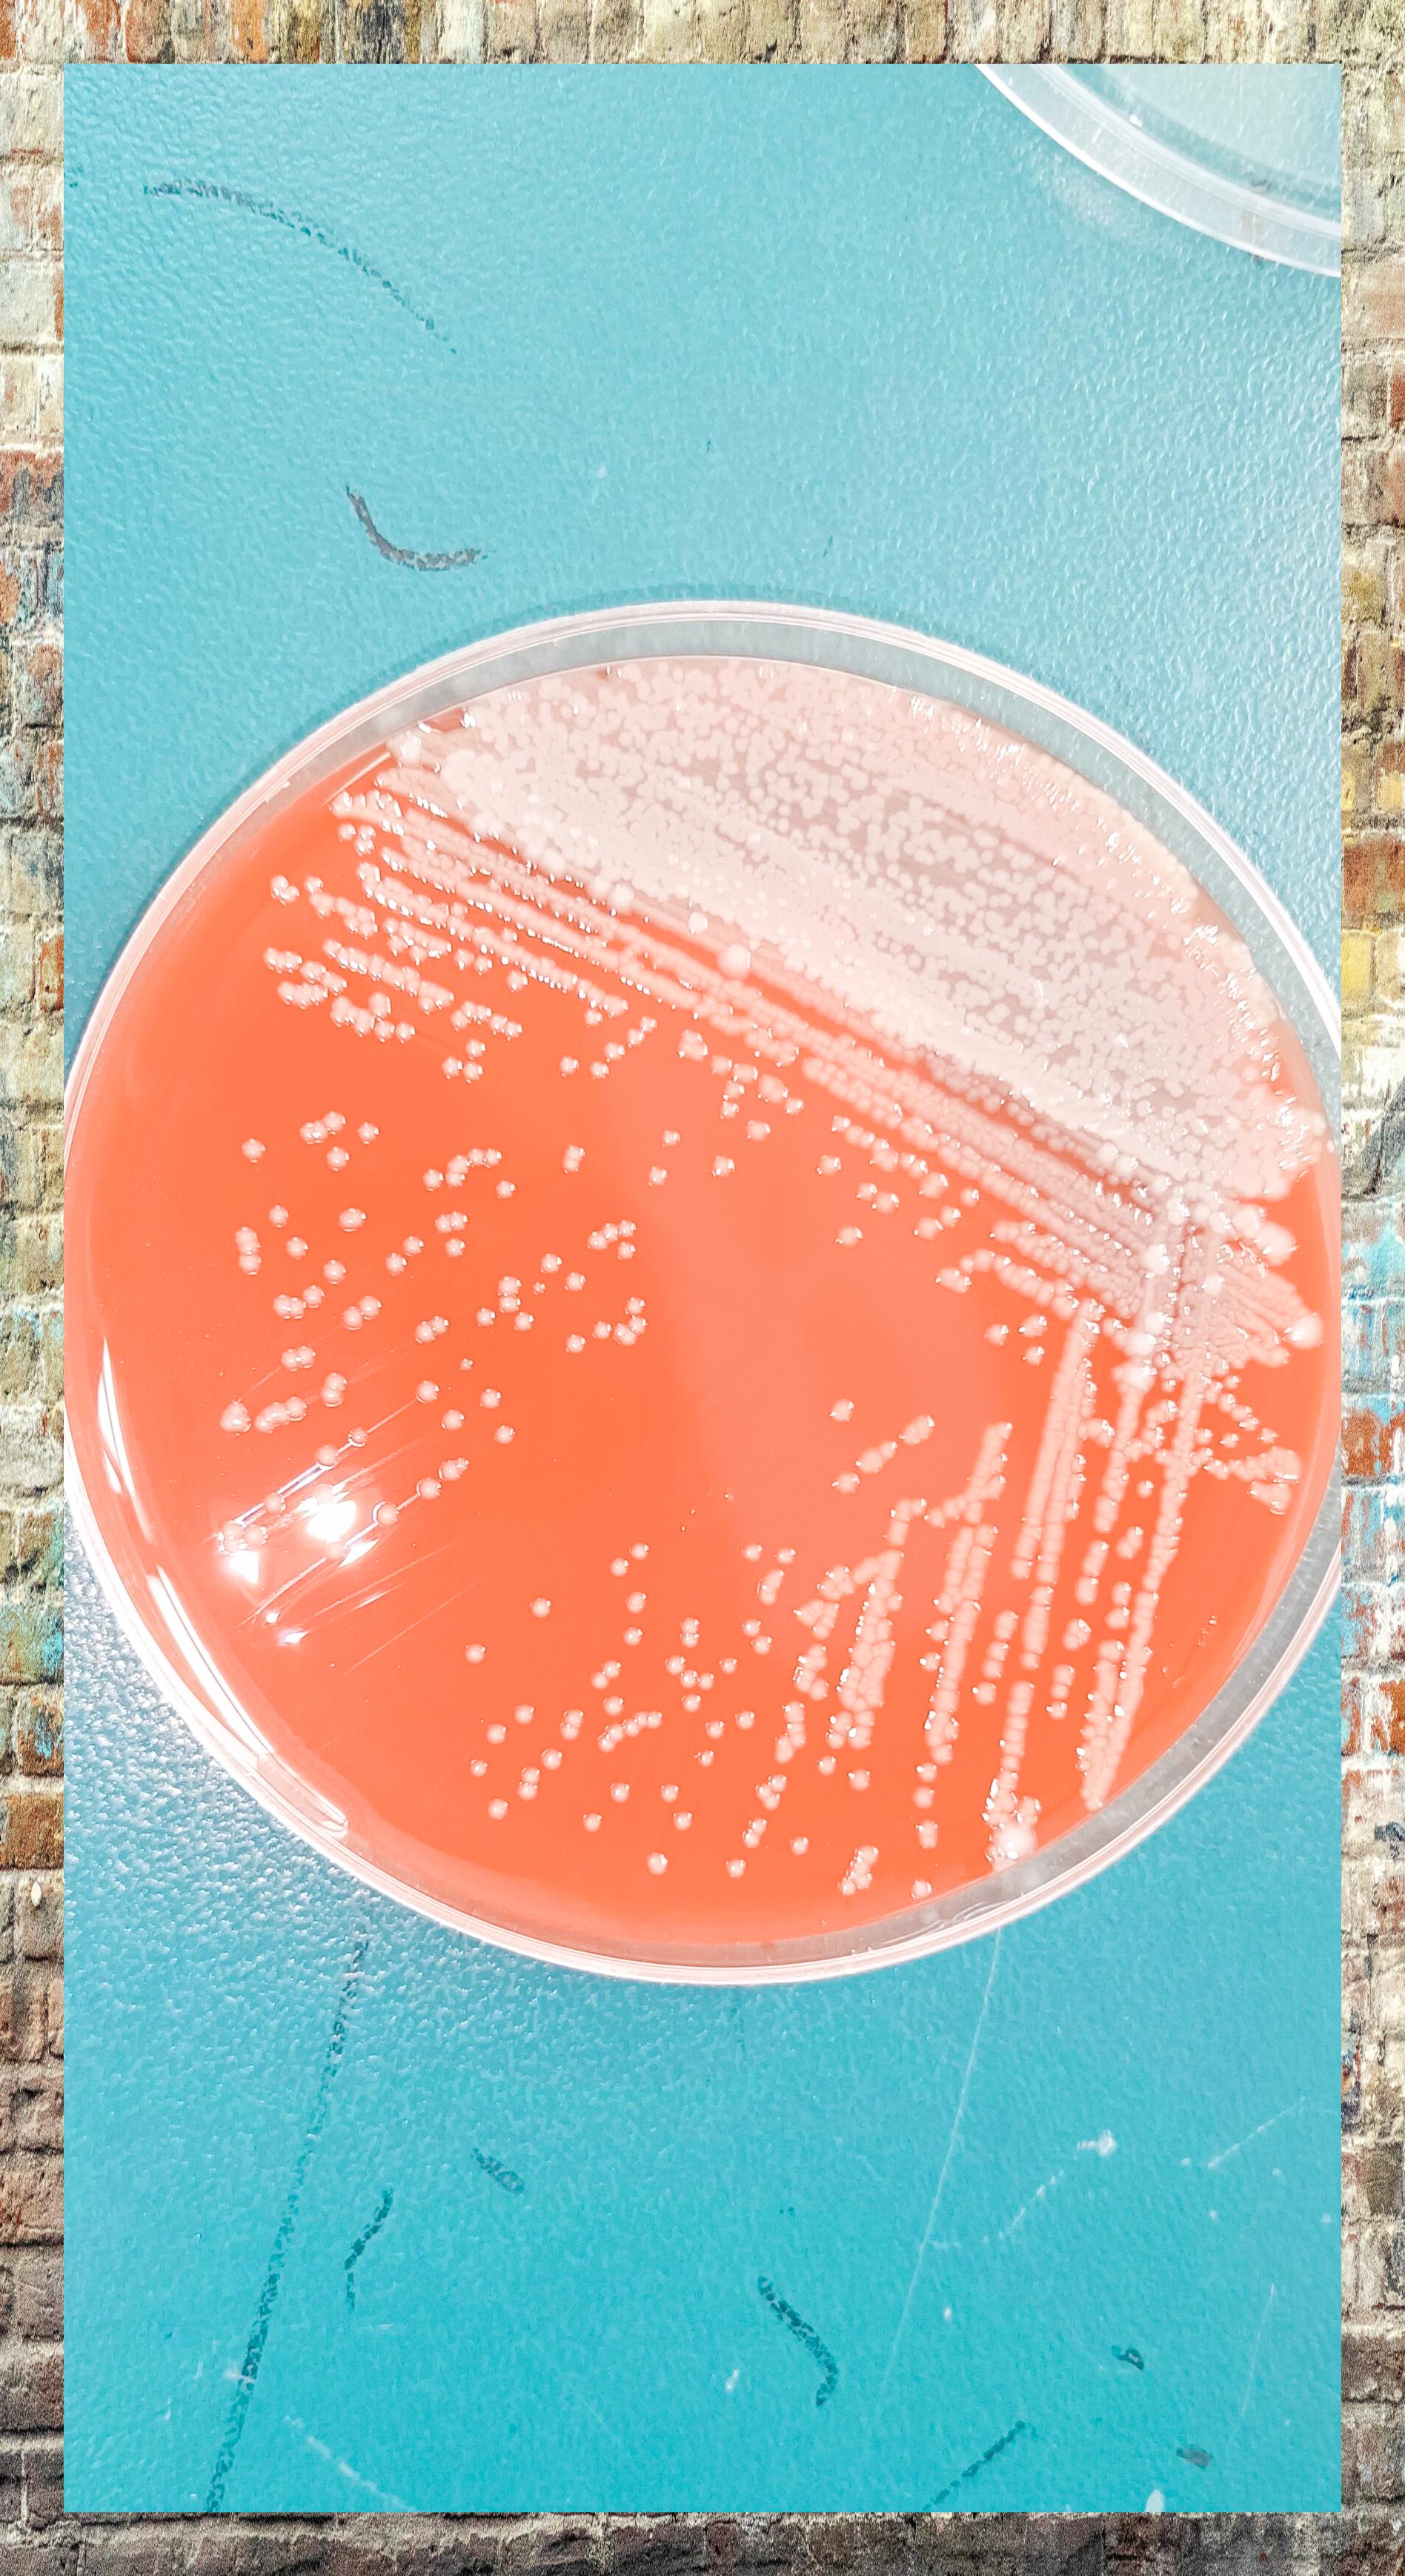
嗜麦芽窄食单胞菌:g
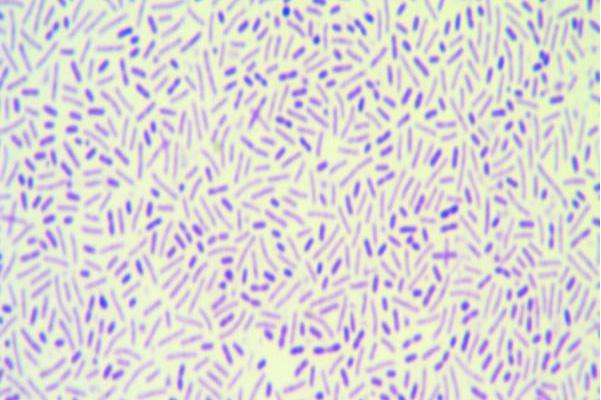
黄色南海杆菌
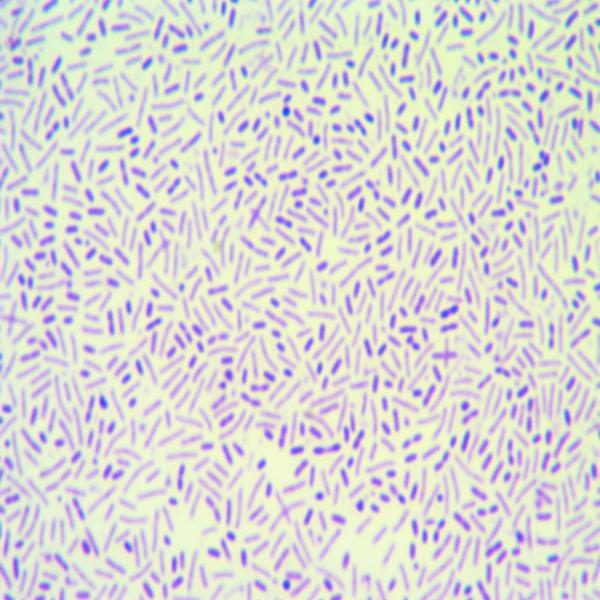
黄色南海杆菌
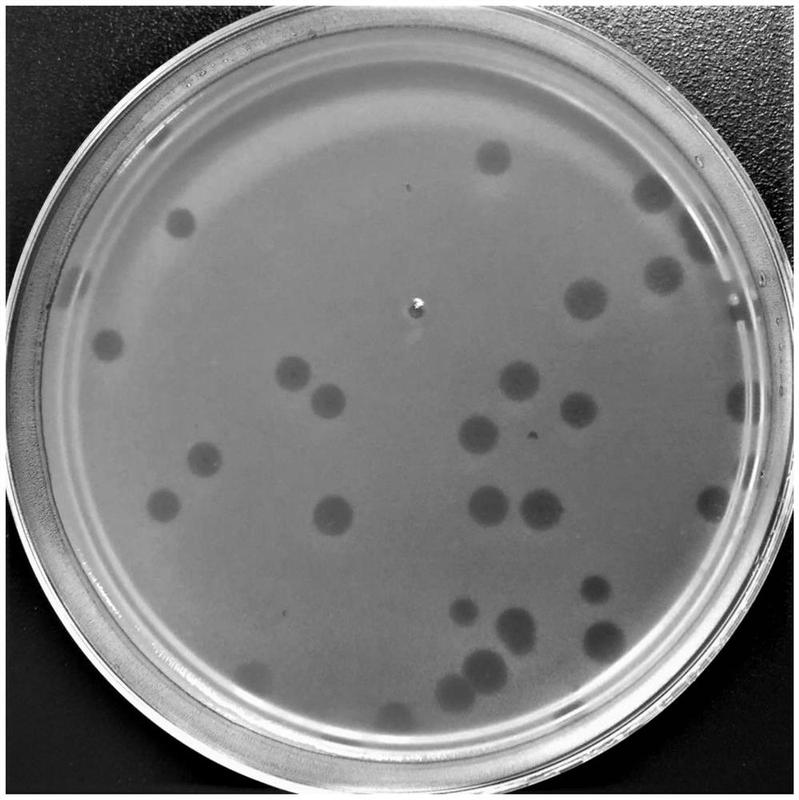
一种地毯草黄单胞菌噬菌体及其组合物,试剂盒和应用

黄单胞杆菌图片
黄单胞杆菌
图片尺寸679x453柠檬溃疡病是由野油菜黄单孢菌柑橘致病
图片尺寸624x436嗜麦芽黄单胞菌
图片尺寸800x520柠檬溃疡病是由野油菜黄单孢菌柑橘致病
图片尺寸718x693
铜绿假单胞菌,黄杆菌
图片尺寸1920x1445
树生黄单胞菌现2
图片尺寸320x280黄色金黄杆菌
图片尺寸601x400图片尺寸909x529

嗜麦芽窄食单胞菌:g
图片尺寸1896x3476形态观察:嗜麦芽窄食单胞菌是革兰阴性杆菌,具有1
图片尺寸1080x1050
黄单胞菌种群多样性和毒力因子以及植物
图片尺寸1080x775🧬 探秘黄不拉几的藤黄微球菌 💥
图片尺寸1080x1146黄色南海杆菌
图片尺寸601x400柑桔溃疡病是由地毯黄单胞杆菌引起的,发生在图片尺寸627x419
黄色南海杆菌
图片尺寸600x600铜绿假单胞菌的那些事儿 🌿
图片尺寸1440x1050
🌿黄连粉末的显微世界🔍
图片尺寸1080x1410
藤黄微球菌
图片尺寸1706x1280
一种地毯草黄单胞菌噬菌体及其组合物,试剂盒和应用
图片尺寸799x800
藤黄微球菌
图片尺寸1706x1280

图片尺寸909x529
图片尺寸909x529